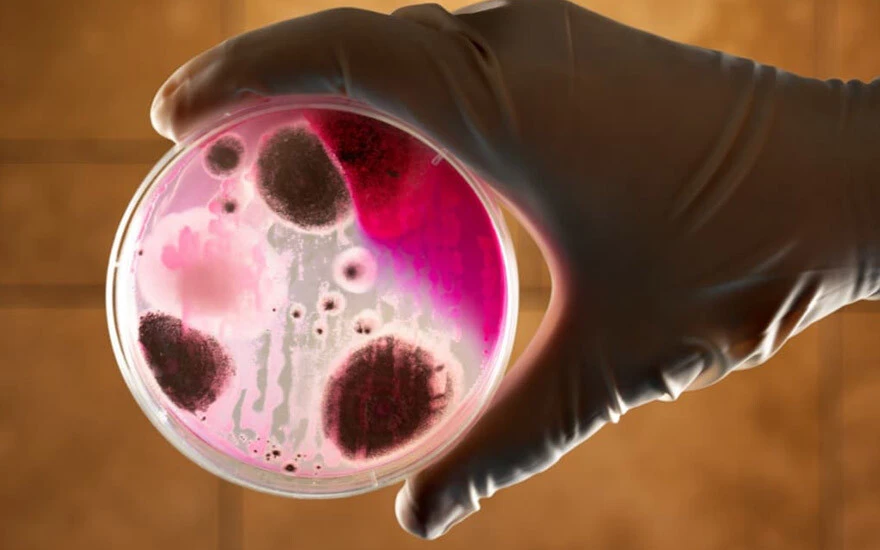
Samsun'da şarbon alarmı! Hayvan kesilmesi yasaklandı

Kategoriler
UYGULAMALAR
İstanbul

Kurban Bayramı öncesi Samsun’da bir ilçede çıkan şarbon tehlikesi vatandaşları tedirgin etti. Terme İlçe Hayvan Sağlığı ve Zabıtası Komisyonundan, ilçeye bağlı Kumcağız Mahallesi’nde şarbon hastalığının görülmesi üzerine açıklama yapıldı.
Yapılan açıklamada şu ifadeler yer aldı:
''Kumcağız Mahallemizde bulunan bir hayvancılık işletmesinde şarbon hastalığı tespiti nedeniyle komisyon kararımız gereğince hayvanların kullandığı mera ve su kaynaklarını içine alacak şekilde Kumcağız Mahallemiz kordon altına alınmıştır. İlçe Tarım ve Orman Müdürlüğünce hayvanlara şarbon aşısı yapılmıştır.
Hastalık sönüşü yapılıncaya kadar hayvanların barınakların dışına çıkartılması kesinlikle yasaktır. Kordon bölgesinde aşılanan tüm hayvanlar için, uygulanan aşının yasal arınma süresinin 21 gün olduğu ve bu süre dolmadan (21 gün) aşı uygulanan hayvanların etlerinin insan tüketimine uygun olmadığı ve 13 Temmuz 2023 tarihine kadar insan tüketimi amacıyla hayvan kesilmesi yasaktır. Hasta ve hastalıktan şüpheli hayvanların bulunduğu yere çıplak ayakla girilmemelidir.

Hayvan bakıcılarının ellerinde ve açık yerlerinde yara bulunmamalıdır. Bu hastalıktan ölen hayvanların uygun bir şekilde ortadan kaldırılması amacıyla ölen hayvanların iki metre derinlikteki çukurlara bulaşık toprak ve altlıkla birlikte yakılarak veya üzerlerine sönmemiş kireç dökülerek gömülmesi sağlanmalıdır. Hasta ve hastalıktan şüpheli hayvanların kesilmesi ve etlerinin tüketilmesi yasaktır.
Deri, kıl, yapağı, süt, boynuz ve tırnakları yakılarak ya da gömülerek imha edilir. Hasta ve hastalıktan şüpheli hayvanların bakım ve beslenmesinde kullanılan malzemeler temizlik ve dezenfeksiyonu yapılmadan sağlıklı hayvanlar için kullanılmamalıdır. Hasta ve hastalıktan şüpheli hayvanların yem ve su kapları bulundukları yerden dışarı çıkarılmamalı, diğer hayvanlar için kullanılmamalıdır. Şarbon hastalığının sönüşüne kadar kordon altına alınan bölgeye aşısız tek tırnaklı, sığır, koyun, keçi girmesi yasaktır. Hastalık görülen mihrakta bulunan büyükbaş, küçükbaş ve tek tırnaklıların tamamı beş yıl boyunca aşılanacaktır. Komisyonca alınan idari ve fenni tedbirlere uymayanlar hakkında 5996 sayılı Kanun gereğince 46 bin 159 TL idari para cezası uygulanacaktır. Üreticilerimize ilanen duyurulur.''